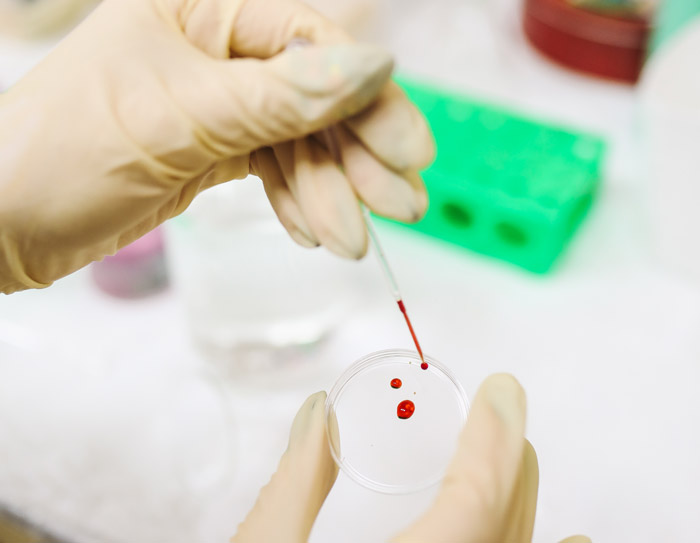
什么是基因筛查？与常规体检大不同

众所周知,任何精密的仪器都有一本产品说明书,按照说明书正确操作,不仅让机器运作更顺畅,还可以延长它的使用寿命。同样,我们人类的身体就像一台精密的仪器,需要小心翼翼地呵护,才能有更长的寿命。
基因筛查,就是我们人体的使用说明书!
众所周知,任何精密的仪器都有一本产品说明书,按照说明书正确操作,不仅让机器运作更顺畅,还可以延长它的使用寿命。同样,我们人类的身体就像一台精密的仪器,需要小心翼翼地呵护,才能有更长的寿命。
基因筛查,就是我们人体的使用说明书!
基因筛查与常规体检皆可起到预防作用,因此很多人经常混淆二者,事实上他们却存在本质上的区别。
常规体检关注的是疾病本身,主要针对人体已出现的症状进行诊断和治疗,它的主要任务是配合疾病的治疗,但无法预知。而基因筛查则是预测疾病发生的风险,进而制定有针对性的预防方案。
很多疾病无明显症状,一旦发病,传统体检便会变得十分被动与滞后,而基因筛查作为传统检查的指南,能够使疾病预防变得更具前瞻性和个性化,因此基因筛查与常规体检二者缺一。
既然基因筛查如此重要,那什么是基因筛查?简单来说,基因筛查是通过人体血液或其他组织细胞中提取DNA物质,用荧光定量PCR、测序仪、基因芯片等特定设备测序,分析序列基因类型及基因特点,检测序列是否排列有缺陷以及其功能表达是否正常。当被检者拿到基因筛查报告后,医生将结合其家族史、临床表现、其他辅助检查结果等,从而得出最终诊断。
● 健康人群
基因筛查可以帮助健康人群发现疾病易感基因,了解部分疾病的发生风险,积极采取合理的健康管理方案,有效延缓甚至阻止疾病的发生。
● 亚健康人群
长期吸烟、饮酒及生活不规律、长期处于污染较严重环境等人群,通过基因筛查了解自身基因情况,不仅可以科学制定健康管理方案,还可以及早发现疾病和了解患病原因。
此外,如果你符合以下任何一种情况,建议应尽快做基因筛查:
● 癌症家族史人群
部分癌症具有一定的家族遗传倾向,如果家族中有这类癌症患者,其后代患癌症的几率相对增加,建议及早进行癌症基因检测,以采取有效的预防措施,而具有遗传倾向的常见癌症包括乳腺癌、多发性结肠癌、宫颈癌等。
● 心脑血管疾病患者
原发性心肌病变是遗传性的心脏肌肉疾病,该疾病会增加心肌收缩及输出的负担,最终可导致不能修补的心脏功能问题,当中常见的是肥厚型心肌病,主要由成因不明的心脏肌肉肥厚引致。遗传性心血管疾病基因筛查,针对与家族性肥厚型心肌病、原发性扩张型心肌病、肌球蛋白储积型肌病等心肌病变有关的MYH7基因。这个基因筛查有助识别原发性心肌病变基因的携带者,以便向心脏专科医生了解潜在风险及采取有效的预防措施。
● 孕妇
基因筛查中的无创产前基因检测,正是为此类人群而研发的,此外还有地中海基因检测、隐性基因疾病检测等。无创产前基因检测只需要抽取母体少量静脉血液,便可得知胎儿的遗传信息,从而检测胎儿是否患上唐氏综合征、爱德华综合征、帕陶综合征等染色体疾病。与传统唐氏筛查(超声波检查、血清筛检法)相比,此类检测方法准确率更高可达90%以上,还可避免了因为侵入性诊断带来流产、感染风险。
● 身体出现不适症状
已患病者在接受就诊的同时,如果想知道治疗效果,可以通过基因筛查获知疗效,如果对部分治疗药物具有耐药性,可以及早更换治疗方案,以保证治疗效果,延缓疾病带来的痛苦,提高生命质量。
香港化验所表示,利用基因筛查通过对这些基因序列进行分析与解读,我们可以对体内的一些生理活动进行评估,有助于了解与把握自己身体的生理功能,比如:
☞ 评估肿瘤易感风险
肿瘤可以说是一种基因疾病,即在某些环境因素(如辐射、化学物质、生物毒素等)影响下,染色体上的NA会发生损伤,导致细胞对生长失去调控能力,开始恶性增生,引起癌症。
☞ 评估慢性疾病易感风险
慢性疾病的发生通常受很多因素影响,遗传便是其中一项重要的因素,通过对基因筛查了解被检者自身的基因序列中是否存在某些“疾病易感位点”,进而评估患病风险。
☞ 营养代谢
我们日常摄入的各类食物,在体内要经过一系列的化学代谢反应,才能最终发挥作用,而基因的差异,决定不同人对食物的代谢能力是有差异的。通过基因筛查,我们可以评估自身的代谢能力,以调整日常对营养物的需求量。
☞ 用药指导
与营养物质的代谢相似,我们服用的药物同样需要在体内经过一系列大些反应,而基因的差异,决定不同人的代谢能力对药物的疗效、使用剂量以及药效持续时长。通过基因筛查,我们可以评估自身的代谢能力,以确定有效的药物治疗方案。
总的来说,基因筛查可以帮助我们更了解自己的身体,以绕开“疾病”的雷区。除此之外,别忘记,坚持健康的生活方式,增强免疫力,同样是延缓或预防疾病发生的重要手段!

完成測試後,有機會獲免費骨質密度檢查 (DEXA) 乙次 或 骨質密度檢查優惠券乙張
閣下資料將會用作此推廣活動聯絡用途,如因資料有誤而未能聯絡閣下,本公司一概不負上任何責任。